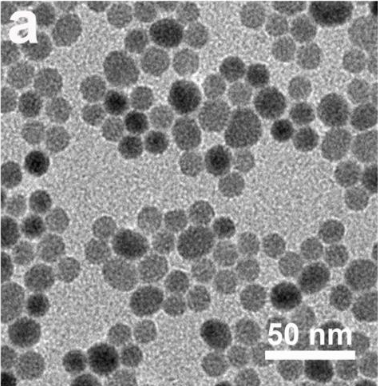

名稱:NaGdF4
組成:Na Gd F4
粒徑:10-30nm
應用:靶向細菌的NIR-II光聲成像
儲存條件:-4℃
其他說明:密封狀態下保質期半年【主要優勢】新的探針保留了原有探針的穩定性,安全性與熒光特征,并可以在體內外和革蘭氏陽性細菌特異性結合。這可以用于開發體內細菌感染的早期診斷試劑,為實驗室和臨床診斷細菌感染提供便捷
題目:
NaGdF4:Nd@NaGdF4 Core-ShellDown-Conversion Nanoparticles as NIR-II Fluorescent Probes for Targeted Imagingof Bacteria文章鏈接:
https://www.antpedia.com/news/wx_article/687415.html
留言咨詢
|
|
 |
| 生物納米材料前沿 |
 |
| 納米醫學Frontier |
|
溫馨提示:蘇州北科納米供應產品僅用于科研,不能用于人體,不同批次產品規格性能有差異。網站部分文獻案例圖片源自互聯網,圖片僅供參考,請以實物為主,如有侵權請聯系我們立即刪除。
提示說明:納米材料工藝和制備可能會有改變 所有納米材料均支持按需定制 下單前聯系客服確認產品詳細信息。 |